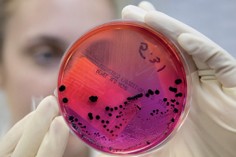

Saúde
Covid-19: Hospital de Leiria suspende estágios e restringe visitas
Medidas preventivas face ao risco de contágio pelo novo coronavírus

O Centro Hospitalar de Leiria (CHL) anunciou que restringiu o horários e o número de visitantes aos doentes internatos e suspendeu os estágios dos estudantes face ao risco elevado de contágio pelo novo coronavírus.
O Conselho de Administração (CA) explicou, numa nota de imprensa, que "restringiu as visitas aos seus pacientes internados, devido ao actual grau de ameaça da epidemia causada pelo coronavírus".
Esta medida, entre outras, insere-se nos mecanismos de prevenção que são agora actualizados e entra em vigor já no próximo dia 8 de Março.
O Conselho de Administração do CHL justifica a adopção de mais medidas preventivas tendo em conta que existe, “neste momento, um risco moderado a elevado de importação de casos de coronavírus e, não obstante as medidas que venham a ser implementadas no âmbito do plano de contingência”.
Nesse sentido, o CA decidiu suspender as visitas, restringindo a entrada a um acompanhante/cuidador, sem a possibilidade de troca, nos serviços de internamento, no horário em vigor (12 às 20:30 horas).
Serão ainda suspensas as entradas de acompanhantes de doentes em observação nos Serviços de Urgência Geral do HSA e Urgências Básicas do Hospital Distrital de Pombal e Hospital Bernardino Lopes de Oliveira, em Alcobaça, com a excepção de acompanhantes de doentes vulneráveis.
No Serviço de Pediatria (internamento e urgência) só é permitida a entrada de um acompanhante. O mesmo se passa no Serviço de Urgência Ginecológica/Obstétrica, onde apenas quem está com a grávida só pode ir até à sala de partos, estando suspenso o acesso ao bloco operatório central.
Medidas que têm efeito a partir deste domingo, dia 8.
O CHL refere ainda que vai suspender todas as actividades com entidades externas (formações, reuniões, sessões clínicas, etc.) e todas as actividades internas que envolvam profissionais de mais de um serviço (reuniões, formações, etc.) deverão ser alvo de uma avaliação de risco, para decidir sobre a sua realização.
Vão ainda ser Suspensos todos os estágios que se encontram a decorrer e os que estejam previstos.
Todas as actividades presenciais relacionadas com visitas de promotores externos e monitorização de estudos clínicos deixam de se realizar, assim como as sessões de preparação para o parto e circuito de visita guiada pré-natal.
O atendimento presencial no Serviço de Gestão de Recursos Humanos está suspenso, devendo os profissionais contactar com esse serviço através de telefone (244 817 012 – Ext. 7001 e 7003), ou por email (sgrh.geral@chleiria.min-saude.pt).
As cerimónias religiosas da capela do Hospitala de Santo André não vão existir nos próximos tempos.
A restauração e os refeitórios dos três hospitais do CHL estão restritos ao acesso a profissionais. Os acompanhantes com direito a refeição deverão ser servidos nos respectivos serviços de internamento.
O CA do CHL informa ainda que “encontrando-se o grau de risco em constante avaliação pelas entidades competentes da área governativa da saúde, as medidas agora enunciadas serão monitorizadas e divulgadas a sua actualização ou reposição”.